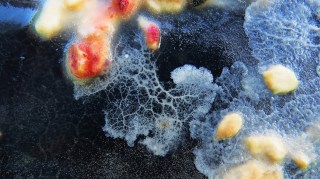

Publicado en el blog de Martín Monteiro .
Léelo completo en su sitio: http://fisicamartin.blogspot.com/2019/06/redlcc-2019-semana-22.html
Domingos de divulgación científica con algunas de las mejores notas de la semana en la Red Latinoamericana de Cultura Científica
Semana #22 – 26 de mayo al 2 de junio
#RedLCC #DivulgaCiencia #ComunicaCiencia
1 de 3) BioArte: arte & ciencia
Por AcercaCiencia
2 de 3) Grupo liderado por científicos uruguayos abre nuevas posibilidades para tratamiento del cáncer
Por SobreCiencia
3 de 3) CALENDARIO JUNIO 2019: HITOS DE CIENCIA Y TECNOLOGÍA EN AMÉRICA LATINA: TELEVISIÓN A COLOR: MÉXICO
Por Revista Persea
Puedes seguir a la Red LCC en la web: https://redlcc.org/
En Twitter: @RedLCC
En Facebook: Red LatCC
La Red Latinoamericana de Cultura Científica es un esfuerzo conjunto de divulgadores latinoamericanos para contribuir con la comunicación de contenidos de ciencia y tecnología desde nuestra región y en particular para revalorizar la ciencia en las redes sociales.
https://redlcc.org/wp-content/uploads/2019/06/da1c6-screenshot_20190602-184906_photos.jpg?w=300